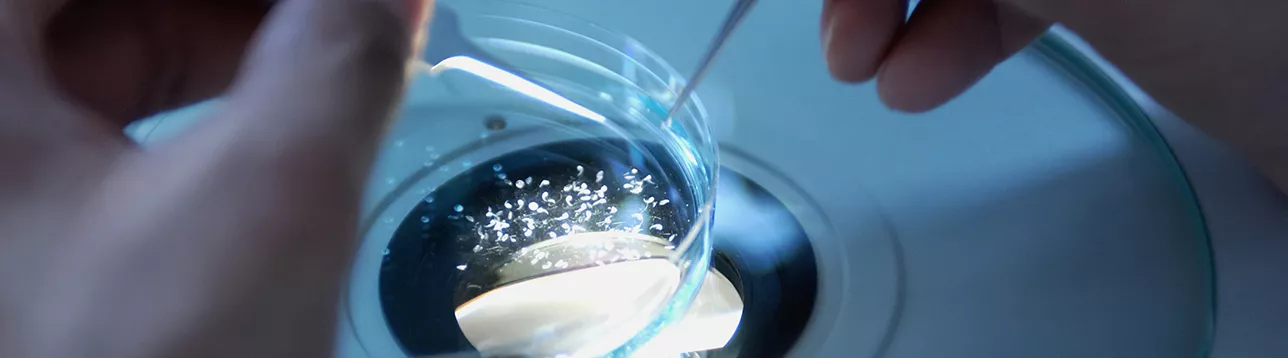

Cancer research
We are at the forefront of cancer research. Our researchers focus both on understanding the underlying mechanisms causing cancer and on clinical trials that can quickly benefit patients.
Cancer is a complex and heterogeneous group of about 200 different diseases, often involving tumours.
Thanks to new developments in research, our understanding of cancer has increased enormously in recent decades. More people are surviving and many are making a full recovery. But the challenges are still considerable, and at least one in three people in Sweden will be diagnosed with cancer in their lifetime.
Diverse research is essential
There are many different cancer research initiatives at Lund University. Our research is dedicated to improving the diagnoses, prognoses, treatment and care related to cancer. The most common cancers in Sweden are breast, prostate, and colorectal cancer.
Researchers in this area are:
- studying more than 30 different types of cancer through basic research, diagnostics and treatment
- delving into the microenvironments of tumours to deepen our knowledge of cancer and to develop new treatment options
- using imaging and radiotherapy to improve available tools in basic research, treatment and diagnostics
- mapping genetic factors and tumour development, leading to more personalised treatment plans for patients
- conducting pioneering research in cancer care, with a special focus on rehabilitation and palliative care
- translating research results to patients through innovative treatments and clinical trials.
Our research is conducted in collaboration with Skåne University Hospital. It covers a broad range – from laboratory studies to clinical trials involving cancer patients; as well as the perspectives of patients and their families.
Application areas
Our researchers are working closely with Skåne University Hospital and other organisations to develop new solutions in areas such as:
Artificial intelligence (AI) and machine learning are creating new ways of analysing images in microscopy or medical diagnostics, for example. This knowledge is paving the way for new discoveries and applications.
Among other things, these methods can be used to streamline healthcare and facilitate diagnostics in low and middle-income countries to improve global health equity.
Pocket-sized ultrasound – an ultrasound device so small that it fits in your pocket – is one such an innovation. It is a smartphone with an algorithm linked to thousands of clinical breast images, providing diagnostics where it is most needed.
Researchers contribute to the development of new Advanced Therapy Medicinal Products (ATMPs).
ATMPs differ from traditional drugs in the way that their active substance is produced in or taken from living cells, genes, tissues, or other biological materials.
This type of therapy includes cell and gene therapy, which is used to cure, treat or alleviate various forms of cancer.
ATMPs have the potential to revolutionise the treatment of disease. CAR-T cells are an example of an ATMP, where CAR stands for chimeric antigen receptor. In this type of therapy, the patient's immune defence cells (T lymphocytes) are modified so that they are specifically activated to target cancer cells.
Experimental models and biobanks are being developed and implemented in cancer research. One example is 3D organoids, a type of mini-organ grown from cells, which are used to model disease progression and treatments.
Such mini-organs help healthcare professionals to improve diagnostics and develop better treatments for cancer patients.
Precision medicine, also known as individualised, personalised or stratified medicine, enables tailor-made prevention, diagnosis, treatment and follow-up. These are adapted to the specific needs of each patient, for example by developing genetic profiles and using specific biomarkers.
The Childhood Cancer pilot project, part of Genomic Medicine Sweden (GMS), of which Lund University is a member, has improved diagnostics for children with cancer in Sweden. Through genetic analyses, children can now receive faster, safer and more detailed diagnoses, increasing the possibility of targeted treatment for childhood cancers.
Research environments
The following links are to other websites.
- Clinical genomics (SciLifeLab Lund)
- Engineering health
- Epidemiology
- Clinical cancer research (Clinical Studies Sweden)
- Nanoscience
- Stem cell research
Collaboration with Region Skåne.
Lund University’s Cancer Centre (LUCC)
LUCC coordinates cancer research at Lund University, providing crucial support for both the university and Region Skåne in making well-informed and strategic decisions in the field.
LUCC serves as the primary contact point for stakeholders and organisations seeking collaboration opportunities in cancer research.
Director
Mats Jerkeman
Professor of Clinical oncology
Mobile: +46(0)70 497 3507
mats [dot] jerkeman [at] med [dot] lu [dot] se (mats[dot]jerkeman[at]med[dot]lu[dot]se)
Scientific coordinator, PhD
Pia Berntsson
Mobile: +46(0)70 213 3876
pia [dot] berntsson [at] med [dot] lu [dot] se (pia[dot]berntsson[at]med[dot]lu[dot]se)
Website
Research database
Related researchers, projects and publications.
Latest news in cancer research

New mechanism revealed: How leukemia cells trick the immune system

AI model from Lund University indicates four out of ten breast cancer patients could avoid axillary surgery
